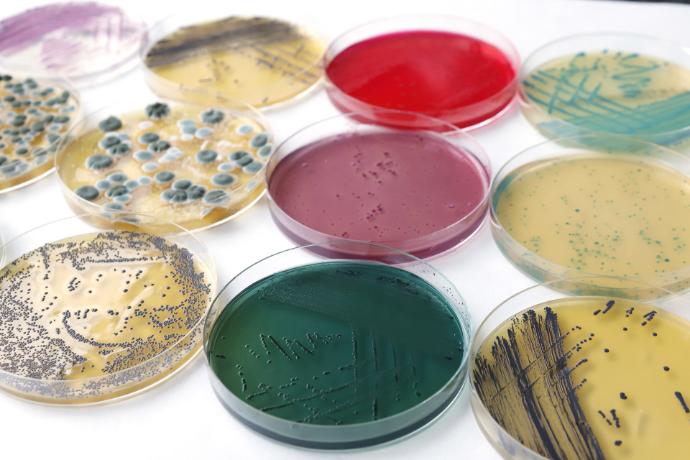

Controles microbiológicos y bioensayos
Compromiso con la seguridad alimentaria a través de ciencia avanzada
Servicios

Calidad higiénico-sanitaria de alimentos
- Implementamos técnicas rápidas y fiables para detectar patógenos y alterantes en productos agroalimentarios.
- Garantizamos cumplimiento normativo y requisitos de mercado con resultados precisos y en el menor tiempo posible, apoyando así la seguridad alimentaria.
- Laboratorio acreditado por ENAC (ISO 17025 / ILAC), lo que facilita el acceso a mercados internacionales al reducir o eliminar la necesidad de controles adicionales.

Estudios de vida útil
- Diseñamos estudios personalizados para determinar fecha de caducidad o consumo preferente de tus productos.
- Evaluamos cómo evoluciona la calidad microbiológica durante la vida útil, garantizando la inocuidad, estabilidad y seguridad alimentaria.
Eficacia y nuevos métodos de conservación
-
Validamos métodos de conservación tradicionales e innovadores, como biopreservación o fermentación controlada.
-
Realizamos bioensayos para medir su impacto en la seguridad microbiológica y asegurar productos seguros y de calidad.

Higiene y desinfección de instalaciones
- Analizamos superficies y ambientes de producción para evaluar la presencia de microorganismos potencialmente peligrosos.
- Aplicamos métodos validados para verificar la eficacia higiénica del entorno laboral.

Control de manipuladores de alimentos
-
Evaluamos el riesgo microbiológico derivado del personal manipulador: higiene, manejo de alimentos y posibles contaminaciones cruzadas..
- Realizamos detección, caracterización y trazabilidad de patógenos en la cadena alimentaria.

Análisis de la calidad del agua
- Disponemos de metodologías para controlar la calidad microbiológica del agua de consumo y piscinas, según la normativa vigente.